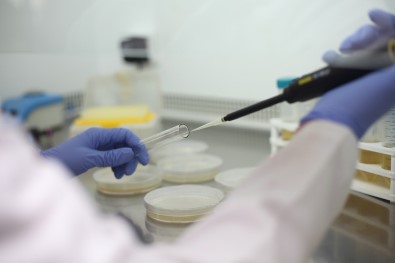

PAÜ'nün 4 Projesi Birden TÜBİTAK Tarafından Destek Aldı
Pamukkale Üniversitesi öğretim üyeleri tarafından çalışmaları sürdürülen 4 proje, 2019 yılı birinci döneminde TÜBİTAK Araştırma Destek Programları Başkanlığı (ARDEB) tarafından destek aldı.
Pamukkale Üniversitesi Tıp Fakültesi Dâhili Tıp Bilimleri Tıbbi Genetik Anabilim Dalı Öğretim Üyesi Prof. Dr. Hakan Akça’nın “miR-3179’un Küçük Hücre Dışı Akciğer Kanseri İnvazyon ve Metastazını Düzenleyici Rolünün in vitro ve in vivo Olarak Saptanması” başlıklı projesi, Fen Edebiyat Fakültesi Kimya Bölümü Öğretim Üyesi Prof. Dr. Metin Ak’ın “Azobenzen İçeren Elektro-aktif ve Foto-aktif Molekül ve Polimerler” konulu projesi, Mühendislik Fakültesi Jeoloji Mühendisliği Bölümü Öğretim Üyesi Prof. Dr. Mehmet Cihat Alçiçek’in “İnegöl Havzası’nın Stratigrafisi ve Tektono-Sedimanter Gelişimi” isimli projesi ve Mühendislik Fakültesi Endüstri Mühendisliği Bölümü Öğretim Üyesi Doç. Dr. Can Berk Kalaycı’nın “Sürdürülebilir Şehir Lojistiği için Etkin Rotalama Algoritmalarının Geliştirilmesi” adlı projesi TÜBİTAK ARDEB tarafından desteklenen projeler arasında yer aldı. Pamukkale Üniversitesi Tıp Fakültesi Dâhili Tıp Bilimleri Tıbbi Genetik Anabilim Dalı Öğretim Üyesi ve Pamukkale Üniversitesi Kanser Uygulama ve Araştırma Merkezi Müdürü Prof. Dr. Hakan Akça, yürütücüsü olduğu proje hakkında şunları dile getirdi; “Akciğer kanseri, kanser ilişkili ölümler arasında dünyada ilk sıralarda gelmektedir. Akciğer kanseri hastalarının yaklaşık yüzde 90’ı sonunda metastazdan dolayı yaşamını yitirmektedir. İnvazyon, metastazın ilk ve en tehlikeli adımıdır. İnvazyon mekanizmalarının anlaşılması kanserle mücadelede en önemli adımlardan biri olabilir. Bunun için, bu mekanizmadaki her bir parçanın bilinmesi önem arz etmektedir. Son zamanlarda yayınladığımız çalışmalarda AKT/NF-kB yolağının küçük hücre dışı akciğer kanserinde (KHDAK) sürekli aktif olduğunu ve hücresel invazyonu uyardığını gösterdik. Hücresel proseslerdeki önemli rollerinin keşfinden sonra miRNA’ların, kanserinde dâhil olduğu çoğu hastalığın önceden tanısı ve ilerlemesinde büyük rolleri olduğu anlaşılmıştır. Önceki projemizde (112S636) miR-3179’un KHDAK invazyonunu regüle ettiğini ve bu miRNA ekspresyonunun NF-kB tarafından düzenlendiğini başarı ile göstermiş bulunmaktayız. Fakat miR-3179’un bu proseste hangi mekanizmayı/mekanizmaları kullandığı henüz bilinmemektedir. Bu sebeple, bu proje önerisinde biz, miR-3179’un hedef gen(ler)ini in vitro modelde bulmayı amaçladık. miR-3179’un kalıcı olarak transfekte edildiği H1299 ve A549 hücreleri ile miR-3179’un kalıcı olarak inhibe edildiği H1975 ve II-18 hücrelerinin invazyon yeteneğindeki değişiklik invazyon chamber yöntemiyle, metastaz yeteneğindeki değişiklik xenograft modeli (orthotopik model) ile tespit edilecektir. Metastaz tanısı almış ve almamış KHDAK hastalarının parafine gömülü dokularından miR-3179 ve hedef gen(ler)inin ekspresyonları qRT-PCR yöntemi ile analiz edilecektir. Böylece bu proje önerisi ile miR-3179’un KHDAK invazyon ve metastazındaki düzenleyici rolünün moleküler mekanizmalarının anlaşılmasını ve bu miRNA’nın KHDAK metastazında biyobelirteç olarak kullanılma potansiyelini aydınlatmayı hedeflemekteyiz.”
“Azobenzen İçeren Elektro-aktif ve Foto-aktif Molekül ve Polimerler”
Pamukkale Üniversitesi Fen Edebiyat Fakültesi Kimya Bölümü Öğretim Üyesi Prof. Dr. Metin Ak, proje yürütücüsü olduğu çalışma hakkında verdiği bilgilerde şunları aktardı: “Nanoteknolojinin gelişmesi ile birlikte ısı, ışık gibi dış etkilere molekül düzeyinde cevap verebilen moleküler anahtarların (molecular switches) uygulama alanları hayal gücümüzle sınırlı hale gelmiştir. Proje kapsamında ışıkla optik, elektriksel, mekanik, şekil değişikliği gibi birçok özelliklerin tersinir olarak değiştirilebildiği foto-aktif molekül ve polimerler üretilecektir. Moleküler düzeyde güneş enerjisini depolayabilen yüksek verimli termal enerji depolama cihazlarının tasarımı yapılacaktır. Bunun yanında elde edilecek foto-aktif moleküllere holografik litografi tekniği ile kontrollü ışın girişim deseni uygulanarak (SRG-Surface Relief Grating) üç-boyutlu veri depolama, holografik optik elemanların tasarımı, dalga kılavuz filtresi, süper hidrofobik yüzey oluşumu, biyomedikal uygulamalar, optogenetik farmakoloji gibi birçok alanda kullanılabilecek nano boyutta desenlenmiş malzemeler üretilecektir.”
“İnegöl Havzası’nın Stratigrafisi ve Tektono-Sedimanter Gelişimi (KB Anadolu)”
Mühendislik Fakültesi Jeoloji Mühendisliği Bölümü Öğretim Üyesi Prof. Dr. Mehmet Cihat Alçiçek’in yürütücüsü olduğu proje hakkında verdiği bilgiler çerçevesinde şunları kaydetti: “Bölgesel olarak Paratetis paleocoğrafyası içinde yer alan Anadolu yarımadasının oluşumunun ardından gelişen karasal havzalardaki iklimsel süreçler başlıca linyit, bor, trona, manyezit ve huntit gibi zenginliklerin oluşmasına neden olmuştur. Projede KB Anadolu karasal havzaların gelişimini denetleyen iklimsel, tektonik ve jeotermal döngülerin etkileşimi ile oluşan havzaların jeolojik evrimlerinin anlaşılması ile birlikte yaşamsal döngüler ve ekonomik üretim için yönlendirici sonuçlar elde edilecektir.”
“Sürdürülebilir Şehir Lojistiği için Etkin Rotalama Algoritmalarının Geliştirilmesi”
Mühendislik Fakültesi Endüstri Mühendisliği Bölümü Öğretim Üyesi Doç. Dr. Can Berk Kalaycı’nın yürüttüğü proje hakkında verdiği bilgilerde şunları kaydetti: “Yüzyılı aşkın süredir artan fosil yakıt kullanımları dünyada çevresel ve sosyoekonomik birçok sorun ortaya çıkarmıştır. Atmosfere salınan karbondioksitin azaltılması gerekmekte ve fosil yakıt teknolojilerinin yerini sürdürülebilir teknolojilere bırakması büyük önem arz etmektedir. Sürdürülebilir şehir lojistiği, şehir içinde yük araçlarından kaynaklanan problemleri gidermek için çevre dostu araçlar kullanılarak iki kademeli lojistik faaliyetlerin planlanması, sürdürülmesi ve iyileştirilmesidir. Büyüyen şehirlerin lojistik operasyonlarının planlanmasında, enerji israfı, gürültü/kirlilik gibi olumsuz çevresel etkiler ya da trafik sıkışıklığı gibi sorunlar nedeniyle ortaya çıkan şehir lojistiği kavramında amaç düşük maliyet/emisyon ile sosyal yaşamdaki ve ulaştırmadaki verimliliği arttırma ve bu verimliliğin sürdürülebilir kılınmasıdır. Şehir lojistiğinin güncel uygulamalarında, merkez depolardan şehrin çevresindeki uydulara daha büyük araçlarla; uydu depolardan müşterilere ise daha küçük ve çevre dostu araçlar ile dağıtım yapılmaya başlanmıştır. Trafiğe kapalı alanlarda ve pratikte birçok tersine lojistik örneği bulunan dağıtım ağı optimizasyonu uygulamaları sürdürülebilir şehir lojistiğinde öne çıkmaktadır. Artan çevresel/ekonomik kaygılar ve devletlerin fosil yakıtlara olan bağımlılığın azaltılması yönünde aldığı kararlar, elektrikli motor ve batarya teknolojisi alanında yapılan araştırma/geliştirme çalışmalarının da hızlanmasını sağlamıştır. Bu nedenle, elektrikli araçların rotalanması probleminde doğrusal ve doğrusal olmayan şarj süresi ile tam ve parçalı şarj varsayımları üzerine odaklanılmıştır. Her biri farklı özelliklere sahip müşteriler ile şarj istasyonları ve elektrikli araçlardan oluşan bir filonun dağıtım ağının optimize edilmesi bu proje ile hedeflenmektedir. Ele alınan sürdürülebilir şehir lojistiği konusunda yürütülecek çalışmaların uygulama alanları ile ilişkili olarak operasyonel faaliyetlerin bilimsel yaklaşımla daha etkin planlanması hem ekonomik hem de sosyal anlamda fayda sağlayacaktır.”
